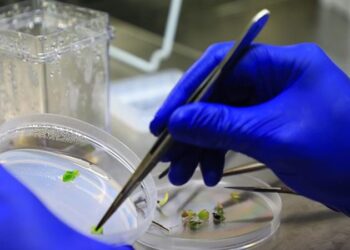
Gökova susamı dondurularak gelecek nesillere aktarılıyor

Gündem
Güncel ve ilgi çekici olayları pozitif bir bakış açısıyla ele alan içerikler.
Bodrum’da ‘Tarımsal Üretimde Kümelenme Modeli’ başlıyor
Bodrum'da 'Tarımsal Üretimde Kümelenme Modeli' başlıyor Bodrum'da 'Tarımsal Üretimde Kümelenme Modeli' projesi hayata geçiriliyor. Yerel üreticiye destek olmayı ve tarım...
Read moreDetailsBeyoğlu’nda budanan ağaç dalları ihtiyaç sahiplerine yakacak oluyor
Beyoğlu’nda budanan ağaç dalları ihtiyaç sahiplerine yakacak oluyor Beyoğlu Belediyesi, ilçe genelinde gerçekleştirdiği ağaç budama işleminden elde edilen ağaç dallarını...
Read moreDetails20 yıldır ‘Kedi çobanı’
20 yıldır 'Kedi çobanı' Kendisini 'Kedi Çobanı' olarak tanımlayan 38 yaşındaki Yasemin Açık, sokak hayvanlarını beslemekle kalmayıp, onlarla yaşıyor. Öyle...
Read moreDetailsGökova susamı dondurularak gelecek nesillere aktarılıyor
Gökova susamı dondurularak gelecek nesillere aktarılıyor Muğla'da yetiştirilen Gökova susamının, özel laboratuvarda dondurularak gelecek nesillere aktarılması sağlanıyor. Muğla Büyükşehir Belediyesinin...
Read moreDetailsBilim insanları buzdan ötegezegenlere buzdan robotlar göndermeyi planlıyor
Bilim insanları buzdan ötegezegenlere buzdan robotlar göndermeyi planlıyor Araştırmacılar, buzdan oluşan ötegezegenlere buzdan yapılma robotlar göndermeyi planlıyor. Independent Türkçe'de yer...
Read moreDetailsYapay zekâ bir kanser türüne daha yardımcı olacak
Yapay zekâ bir kanser türüne daha yardımcı olacak Yapılan yeni bir araştırma, yapay zekânın bağırsak kanseri tanısında da yardımcı olduğunu...
Read moreDetailsALS hastası Özlem, gözlerini kullanarak kitap yazdı
ALS hastası Özlem, gözlerini kullanarak kitap yazdı Düzce’de, 13 yıl önce ALS hastası olduğunu öğrenen, geçen süre içerisinde yatağa bağımlı...
Read moreDetailsÖmrü uzatan yiyecekler açıklandı
Ömrü uzatan yiyecekler açıklandı ABD'li bilim insanları, bitkisel gıdanın, ömrü uzatmaya yardımcı olanlar dahil çeşitli yararlı özelliklere sahip olduğunu söyledi....
Read moreDetailsSony Müzik’ten Türk Prodüktörler Moses & Emr3ygul’e ‘Platin Plak’ ödülü
Sony Müzik’ten Türk Prodüktörler Moses & Emr3ygul’e 'Platin Plak' ödülü Geçen yıl We Are Venom şarkılarıyla isimlerini dünyaya duyuran Türk...
Read moreDetailsAraç içerisine sıkışan kediyi itfaiye kurtardı
Araç içerisine sıkışan kediyi itfaiye kurtardı BURDUR'un Bucak ilçesinde girdiği hafif ticari aracın ön konsol kısmına sıkışan yavru kedi, itfaiye...
Read moreDetails